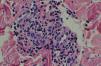
fig3

El síndrome de Sneddon (SS) consiste en la asociación de livedo reticularis y crisis isquémicas cerebrovasculares1. Se considera que es un proceso trombótico, aunque su fisiopatología no se conoce con exactitud, especialmente en los pacientes con anticuerpos antifosfolípidos (aPL) negativos.
Una mujer de 36 años consultó por lesiones asintomáticas en el tronco y las extremidades de 5 años de evolución. Inicialmente las lesiones eran transitorias, pero con el tiempo se habían hecho estables. Desde hacía dos años presentaba episodios de déficits neurológicos focales transitorios (hemiparesia facial izquierda y de la extremidad superior izquierda). Refería cefaleas frecuentes que habían comenzado al mismo tiempo que las alteraciones neurológicas. La paciente tenía historia de hipertensión arterial diastólica desde hacía aproximadamente dos años y de anticonceptivos orales desde hacía más de 10 años. No refería hábitos tóxicos ni historia personal ni familiar de abortos o trombosis venosas.
La exploración física mostraba máculas eritemato-parduzcas, de aspecto reticulado, que ocupaban gran parte de la superficie corporal (fig. 1). Asimismo, presentaba una pequeña escara necrótica en el quinto dedo del pie derecho. Otro hallazgo fueron las lesiones habonosas de morfología reticulada localizadas en ambas mamas, que duraban más de 24h y regresaban sin lesiones residuales (fig. 2).
Se solicitó una analítica, que incluyó hemograma, bioquímica, niveles de calcio y fósforo, anticuerpos antinucleares, anticardiolipina y anticitoplasma de neutrófilo, anticoagulante lúpico, complemento, crioglobulinas, hormonas tiroideas, proteinograma, velocidad de sedimentación globular y serologías de lúes, virus de la hepatitis B y C y virus de la inmunodeficiencia humana y un sedimento urinario; todas fueron normales. El estudio de coagulación mostró una mutación heterocigota del factor V Leiden.
Se realizó una ecografía abdominal que no evidenció alteraciones. La resonancia magnética cerebral mostró lesiones hiperintensas en la sustancia blanca subcortical y en las radiaciones ópticas. La angiografía cerebral y el ecocardiograma fueron normales.
El estudio histopatológico de las lesiones de livedo reveló la existencia de unos vasos profundos con engrosamiento e hiperplasia de su capa media, que se dirigían perpendicularmente hacia la dermis media. La biopsia de los habones de la mama mostró un infiltrado perivascular superficial de linfocitos y neutrófilos con leucocitoclasia sugestiva de urticaria vasculitis (fig. 3). Histopatológicamente la lesión necrótica del pie presentaba una úlcera cutánea cubierta por una escara necrótica y un vaso trombosado recanalizándose en la dermis profunda.
La patogenia del SS es desconocida. El estudio histopatológico de las lesiones cutáneas muestra con frecuencia la oclusión de la luz vascular por la proliferación de la íntima y el cúmulo de células mononucleares, eritrocitos y fibrina2. Se debate si esta oclusión es debida a una disfunción endotelial primaria, a fenómenos trombóticos recurrentes en el contexto de un estado de hipercoagubilidad o a una combinación de ambos mecanismos.
Se han descrito diferentes anomalías de la coagulación en relación con el SS, como la deficiencia familiar de antitrombina III, las modificaciones de la relación activador/inhibidor tisular del plasminógeno y la deficiencia de la proteína Z3,4. En los últimos años se ha sugerido la posible implicación de las mutaciones del factor V Leiden en la patogenia del SS. Esta alteración consiste en una mutación del factor V que lo hace resistente a la acción inhibidora de la proteína C. Su existencia es un conocido factor de riesgo para las trombosis venosas y fenómenos arteriales como accidentes cerebrales.
Pocos casos de esta mutación han sido descritos en el SS hasta la fecha. Su presencia en homocigosis o asociada a aPL positivos es muy rara5,6. Recientemente se ha estimado una prevalencia del factor V Leiden en heterocigosis del 15 y 19% en pacientes con SS y aPL negativo4,7. Esta prevalencia es superior a la estimada en la población general.
Además de livedo reticularis, los pacientes con SS pueden presentar acrocianosis, fenómeno de Raynaud y más raramente necrosis cutánea circunscrita8. La presencia de lesiones de vasculitis es muy infrecuente y se ha visto asociada a lupus eritematoso sistémico (LES). En la bibliografía revisada por nosotros no hemos encontrado ningún SS en el que la vasculitis se manifestase en forma de urticaria vasculitis. En una serie de 78 pacientes con LES, 15 presentaban livedo reticularis moderada o grave y 6 de ellos asociaban lesiones vasculíticas en forma de púrpura palpable, infartos cutáneos o nódulos pernióticos9,10. La livedo reticularis se relacionaba con títulos altos de anticuerpos anticardiolipina, enfermedad renal, alteraciones del sistema nervioso central y vasculitis cutánea. La vasculitis no se demostró histológicamente en las lesiones de livedo reticularis, pero sí en otras lesiones coexistentes9,10. Dos de estos pacientes comenzaron con un cuadro clínico compatible con SS y no cumplieron criterios de LES hasta 3 y 10 años después. Por ello, pacientes como la nuestra, que no cumplen criterios de LES en el momento del diagnóstico, pero con anticuerpos anticardiolipina o lesiones vasculíticas, deben ser seguidas en el tiempo, pues el SS pudiera ser una fase evolutiva inicial de LES.
Como conclusión, presentamos un caso de SS asociado a lesiones vasculíticas en forma de urticaria vasculitis. Esta asociación no ha sido previamente descrita y podría ser un marcador de evolución a LES. La paciente también presentaba una mutación del factor V Leiden, que conjuntamente con la ingesta de anticonceptivos orales podrían ser la causa de un estado de hipercoagulabilidad. Tanto los fenómenos vasculíticos como los trombóticos podrían estar implicados en el desarrollo de las lesiones cutáneas y cerebrales.